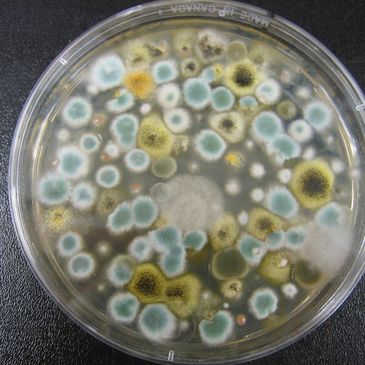

Indoor air quality assessments for fungal spores are all about understanding what’s in the air, why it’s there, and whether it indicates a moisture or contamination problem. The process blends science, inspection, and interpretation — not just collecting numbers.

Asbestos inspections are a critical safety measure used to identify and manage asbestos containing materials (ACMs) in buildings — especially those constructed before 1980. These inspections help protect occupants from exposure to airborne asbestos fibers, which can pose serious health risks.

Asbestos air monitoring is a critical safety practice used to detect and measure airborne asbestos fibers — especially during renovation, demolition, or abatement projects. It ensures that exposure levels remain within legal limits and that protective measures are working as intended.
Such as allergen, water quality, silica, dust, carbon, etc.
Just Ask!
We use cookies to analyze website traffic and optimize your website experience. By accepting our use of cookies, your data will be aggregated with all other user data.